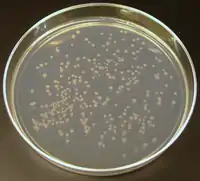

Bacteria
Las bacterias son microorganismos procariotas que presentan un tamaño de unos pocos micrómetros (por lo general entre 0,5 y 5 μm de longitud)[6] y diversas formas, incluyendo esferas (cocos), barras (bacilos), filamentos curvados (vibrios) y helicoidales (espirilos y espiroquetas).[7] Las bacterias son células procariotas, por lo que, a diferencia de las células eucariotas (de animales, plantas, hongos, etc.), no tienen el núcleo definido ni presentan, en general, orgánulos membranosos internos. Generalmente poseen una pared celular y esta se compone de peptidoglicano (también llamado mureína). Muchas bacterias disponen de flagelos o de otros sistemas de locomoción para desplazarse. Del estudio de las bacterias se encarga la bacteriología, una rama de la microbiología.
Aunque el término bacteria incluía tradicionalmente a todos los procariotas, actualmente la taxonomía y la nomenclatura científica los divide en dos grupos. Estos dominios evolutivos se denominan Bacteria y Archaea (arqueas).[2] La división se justifica en las grandes diferencias que presentan ambos grupos a nivel bioquímico y genético. La presencia frecuente de pared de peptidoglicano junto con su composición en lípidos de membrana son la principal diferencia que presentan frente a las arqueas.
Las bacterias son los organismos más abundantes del planeta. Son ubicuas, se encuentran en todos los hábitats terrestres y acuáticos; crecen incluso en los más extremos como en los manantiales de aguas calientes y ácidas, en desechos radioactivos,[8] en las profundidades tanto del mar como de la corteza terrestre. Algunas bacterias pueden incluso sobrevivir en las condiciones extremas del espacio exterior. Se estima que se pueden encontrar en torno a 40 millones de células bacterianas en un gramo de tierra y un millón de células bacterianas en un mililitro de agua dulce. En total, se calcula que hay aproximadamente 5×1030 bacterias en el mundo.[9]
Las bacterias son imprescindibles para el reciclaje de los elementos, pues muchos pasos importantes de los ciclos biogeoquímicos dependen de estas. Como ejemplo cabe citar la fijación del nitrógeno atmosférico. Sin embargo, solamente la mitad de los filos conocidos de bacterias tienen especies que se pueden cultivar en el laboratorio,[10] por lo que una gran parte (se supone que cerca del 90 %) de las especies de bacterias existentes todavía no ha sido descrita.
En el cuerpo humano hay aproximadamente diez veces más células bacterianas que células humanas, con una gran cantidad de bacterias en la piel y en el tracto digestivo.[11] Aunque el efecto protector del sistema inmunológico hace que la gran mayoría de estas bacterias sea inofensiva o beneficiosa, algunas bacterias patógenas pueden causar enfermedades infecciosas, incluyendo cólera, difteria, escarlatina, lepra, sífilis, tifus, etc. Las enfermedades bacterianas mortales más comunes son las infecciones respiratorias, con una mortalidad solo para la tuberculosis de cerca de un millón y medio de personas en 2018.[12] En todo el mundo se utilizan antibióticos para tratar las infecciones bacterianas. Los antibióticos son efectivos contra las bacterias, ya que inhiben la formación de la pared celular o detienen otros procesos de su ciclo de vida. También se usan extensamente en la agricultura y la ganadería en ausencia de enfermedad, lo que ocasiona que se esté generalizando la resistencia de las bacterias a los antibióticos.
En la industria, las bacterias son importantes en procesos tales como el tratamiento de aguas residuales, en la producción de mantequilla, queso, vinagre, yogur, etc., y en la fabricación de medicamentos y de otros productos químicos.[13]
Historia de la bacteriología
._Natuurkundige_te_Delft_Rijksmuseum_SK-A-957.jpeg.webp)
La existencia de microorganismos fue conjeturada a finales de la Edad Media. En el Canon de medicina (1020), Abū Alī ibn Sīnā (Avicena) planteaba que las secreciones corporales estaban contaminadas por multitud de cuerpos extraños infecciosos antes de que una persona cayera enferma, pero no llegó a identificar a estos cuerpos como la primera causa de las enfermedades. Cuando la peste negra (peste bubónica) alcanzó al-Ándalus en el siglo XIV, Ibn Khatima e Ibn al-Jatib escribieron que las enfermedades infecciosas eran causadas por entidades contagiosas que penetraban en el cuerpo humano.[14][15] Estas ideas sobre el contagio como causa de algunas enfermedades se volvió muy popular durante el Renacimiento, sobre todo a través de los escritos de Girolamo Fracastoro.[16]
Las primeras bacterias fueron observadas por el neerlandés Anton van Leeuwenhoek en 1676 usando un microscopio de lente simple diseñado por él mismo.[17] Inicialmente las denominó animálculos y publicó sus observaciones en una serie de cartas que envió a la Royal Society de Londres.[18][19][20] Marc von Plenciz (siglo XVIII) afirmó que las enfermedades contagiosas eran causadas por los pequeños organismos descubiertos por Leeuwenhoek. El nombre de bacteria fue introducido más tarde, en 1828, por Ehrenberg, deriva del griego βακτήριον bacterion, que significa bastón pequeño.[21] En 1835 Agostino Bassi, pudo demostrar experimentalmente que la enfermedad del gusano de seda era de origen microbiano, después dedujo que muchas enfermedades como el tifus, la sífilis y el cólera tendrían un origen análogo. En las clasificaciones de los años 1850 se ubicó a las bacterias con el nombre Schizomycetes dentro del reino vegetal y en 1875 se las agrupó junto a las algas verdeazuladas en Schizophyta.[22]

Louis Pasteur demostró en 1859 que los procesos de fermentación eran causados por el crecimiento de microorganismos, y que dicho crecimiento no era debido a la generación espontánea, como se suponía hasta entonces. (Ni las levaduras, ni los mohos, ni los hongos, organismos normalmente asociados a estos procesos de fermentación, son bacterias). Pasteur, al igual que su contemporáneo y colega Robert Koch, fue uno de los primeros defensores de la teoría microbiana de la enfermedad.[23] Robert Koch fue pionero en la microbiología médica, trabajando con diferentes enfermedades infecciosas, como el cólera, el carbunco y la tuberculosis. Koch logró probar la teoría microbiana de la enfermedad tras sus investigaciones en tuberculosis, siendo por ello galardonado con el premio Nobel en Medicina y Fisiología, en el año 1905.[24] Estableció lo que se ha denominado desde entonces los postulados de Koch, mediante los cuales se estandarizaban una serie de criterios experimentales para demostrar si un organismo era o no el causante de una determinada enfermedad. Estos postulados se siguen utilizando hoy en día.[25]
Aunque a finales del siglo XIX ya se sabía que las bacterias eran causa de multitud de enfermedades, no existían tratamientos antibacterianos para combatirlas.[26] En 1882 Paul Ehrlich, pionero en el uso de tintes y colorantes para detectar e identificar bacterias, descubre la tinción del bacilo de Koch (tinción de Ziehl Neelsen) que poco después es perfeccionada por Ziehl y Neelsen independientemente.[27] En 1884 se descubre la tinción Gram. Ehrlich recibió el premio Nobel en 1908 por sus trabajos en el campo de la inmunología y en 1910 desarrolló el primer antibiótico por medio de unos colorantes capaces de teñir y matar selectivamente a las espiroquetas de la especie Treponema pallidum, la bacteria causante de la sífilis.[28]
Un gran avance en el estudio de las bacterias fue el descubrimiento realizado por Carl Woese en 1977, de que las arqueas presentan una línea evolutiva diferente a la de las bacterias.[29] Esta nueva taxonomía filogenética se basaba en la secuenciación del ARN ribosómico 16S y dividía a los procariotas en dos grupos evolutivos diferentes, en un sistema de tres dominios: Arquea, Bacteria y Eukarya.[30]
Origen y evolución de las bacterias

Los seres vivos se dividen actualmente en tres dominios: bacterias (Bacteria), arqueas (Archaea) y eucariotas (Eukarya). En los dominios Archaea y Bacteria se incluyen los organismos procariotas, esto es, aquellos cuyas células no tienen un núcleo celular diferenciado, mientras que en el dominio Eukarya se incluyen las formas de vida más conocidas y complejas (protistas, animales, hongos y plantas).
El término «bacteria» se aplicó tradicionalmente a todos los microorganismos procariotas. Sin embargo, la filogenia molecular ha podido demostrar que los microorganismos procariotas se dividen en dos dominios, originalmente denominados Eubacteria y Archaebacteria, y ahora renombrados como Bacteria y Archaea,[33] que evolucionaron independientemente desde un ancestro común. Estos dos dominios, junto con el dominio Eukarya, constituyen la base del sistema de tres dominios, que actualmente es el sistema de clasificación más ampliamente utilizado en bacteriología.[34]
El término Mónera, actualmente en desuso, en la antigua clasificación de los cinco reinos significaba lo mismo que procariota, y así sigue siendo usado en muchos manuales y libros de texto.
Los antepasados de los procariotas modernos fueron los primeros organismos (las primeras células) que se desarrollaron sobre la tierra, hace más de 4.350 millones de años. Durante cerca de 3000 millones de años más, todos los organismos siguieron siendo microscópicos, siendo probablemente bacterias y arqueas las formas de vida dominantes.[35][36] Aunque existen fósiles bacterianos, por ejemplo los estromatolitos, al no conservar su morfología distintiva no se pueden emplear para estudiar la historia de la evolución bacteriana, o el origen de una especie bacteriana en particular. Sin embargo, las secuencias genéticas sí se pueden utilizar para reconstruir la filogenia de los seres vivos, y estos estudios sugieren que arqueas y eucariotas están más relacionados entre sí que con las bacterias.[37]
Se ha sugerido que el último antepasado común universal de bacterias y arqueas es un termófilo que vivió hace 4350 millones de años durante el Hádico. La bifurcación entre arqueas y bacterias se produjo a mediados del Hádico, mientras que los eucariotas son más recientes y surgieron a comienzos del Paleoproterozoico. La mayoría de los filos bacterianos se originaron durante el Arcaico. Las bacterias termófilas y las bacterias ultrapequeñas (CPR) se separaron del resto de las bacterias a finales del Hádico y a comienzos del Arcaico. Los grandes clados bacterianos Gracilicutes y Terrabacteria se originaron a mediados del Arcaico.[38][31][32]
En la actualidad se discute si los primeros procariotas fueron bacterias o arqueas. Algunos investigadores piensan que Bacteria es el dominio más antiguo con Archaea y Eukarya derivando a partir de él,[34] mientras que otros consideran que el dominio más antiguo es Archaea.[39][40][41] En cambio, otros científicos sostienen que tanto Archaea como Eukarya son relativamente recientes (de hace unos 900 millones de años)[42][43] y que evolucionaron a partir de una bacteria Gram-positiva (probablemente una actinobacteria), que mediante la sustitución de la pared bacteriana de peptidoglicano por otra de glucoproteína daría lugar a un organismo Neomura.[44][45]
Las bacterias también han estado implicadas en la segunda gran divergencia evolutiva, la que separó Archaea de Eukarya. Se considera que las mitocondrias de las eucariotas proceden de la endosimbiosis de una proteobacteria alfa.[46][47] En este caso, el antepasado de las eucariotas, que posiblemente estaba relacionado con las arqueas (el organismo Neomura), ingirió una proteobacteria que, al escapar a la digestión, se desarrolló en el citoplasma y dio lugar a las mitocondrias. Estas se pueden encontrar en todas las eucariotas, aunque a veces en formas muy reducidas, como en los protistas amitocondriales. Después, e independientemente, una segunda endosimbiosis por parte de alguna eucariota mitocondrial con una cianobacteria condujo a la formación de los cloroplastos de algas y plantas. Se conocen incluso algunos grupos de algas que se han originado claramente de acontecimientos posteriores de endosimbiosis por parte de eucariotas heterótrofos que, tras ingerir algas eucariotas, se convirtieron en plastos de segunda generación.[48][49]
Morfología bacteriana

Las bacterias presentan una amplia variedad de tamaños y formas. La mayoría presentan un tamaño diez veces menor que el de las células eucariotas, es decir, entre 0,5 y 5 μm. Sin embargo, algunas especies como Thiomargarita namibiensis y Epulopiscium fishelsoni llegan a alcanzar los 0,5 mm y la más grande conocida: Thiomargarita magnifica alcanza entre los 10 y 20 mm lo cual la hace visible a simple vista.[50][51] En el otro extremo se encuentran las bacterias más pequeñas conocidas, entre las que cabe destacar las pertenecientes a la clase Mollicutes que incluye al género Mycoplasma y las bacterias ultrapequeñas (Patescibacteria o grupo CPR), las cuales llegan a medir solo 0,3 μm, es decir, tan pequeñas como los virus más grandes.[52]
La forma de las bacterias es muy variada y, a menudo, una misma especie adopta distintos tipos morfológicos, lo que se conoce como pleomorfismo. De todas formas, podemos distinguir tres tipos fundamentales de bacterias:
- Coco (del griego kókkos, grano): de forma esférica.
- Diplococo: cocos en grupos de dos.
- Tetracoco: cocos en grupos de cuatro.
- Estreptococo: cocos en cadenas.
- Estafilococo: cocos en agrupaciones irregulares o en racimo.
- Bacilo (del latín baculus, varilla): en forma de bastoncillo.
- Formas helicoidales:
- Vibrio: ligeramente curvados y en forma de coma, judía, cacahuete o arriñonado.
- Espirilo: en forma helicoidal rígida o en forma de tirabuzón.
- Espiroqueta: en forma de tirabuzón (helicoidal flexible).
Algunas especies presentan incluso formas tetraédricas o cúbicas.[53] Esta amplia variedad de formas es determinada en última instancia por la composición de la pared celular y el citoesqueleto, siendo de vital importancia, ya que puede influir en la capacidad de la bacteria para adquirir nutrientes, unirse a superficies o moverse en presencia de estímulos.[54][55]
A continuación se citan diferentes especies con diversos patrones de asociación:
- Neisseria gonorrhoeae en forma diploide (por pares).
- Streptococcus en forma de cadenas.
- Staphylococcus en forma de racimos.
- Actinobacteria en forma de filamentos. Dichos filamentos suelen rodearse de una vaina que contiene multitud de células individuales, pudiendo llegar a ramificarse, como el género Nocardia, adquiriendo así el aspecto del micelio de un hongo.[56]

Las bacterias presentan la capacidad de anclarse a determinadas superficies y formar un agregado celular en forma de capa denominado biopelícula o biofilme, los cuales pueden tener un grosor que va desde unos pocos micrómetros hasta medio metro. Estas biopelículas pueden congregar diversas especies bacterianas, además de protistas y arqueas, y se caracterizan por formar un conglomerado de células y componentes extracelulares, alcanzando así un nivel mayor de organización o estructura secundaria denominada microcolonia, a través de la cual existen multitud de canales que facilitan la difusión de nutrientes.[57][58] En ambientes naturales tales como el suelo o la superficie de las plantas, la mayor parte de las bacterias se encuentran ancladas a las superficies en forma de biopelículas.[59] Dichas biopelículas deben ser tenidas en cuenta en las infecciones bacterianas crónicas y en los implantes médicos, ya que las bacterias que forman estas estructuras son mucho más difíciles de erradicar que las bacterias individuales.[60]
Por último, cabe destacar un tipo de morfología más compleja aún, observable en algunos microorganismos del grupo de las mixobacterias. Cuando estas bacterias se encuentran en un medio escaso en aminoácidos son capaces de detectar a las células de alrededor, en un proceso conocido como percepción de quórum, en el cual todas las células migran hacia las demás y se agregan, dando lugar a cuerpos fructíferos que pueden alcanzar los 0,5 mm de longitud y contener unas 100 000 células.[61] Una vez formada dicha estructura las bacterias son capaces de llevar a cabo diferentes funciones, es decir, se diferencian, alcanzando así un cierto nivel de organización pluricelular. Por ejemplo, entre una y diez células migran a la parte superior del cuerpo fructífero y, una vez allí, se diferencian para dar lugar a un tipo de células latentes denominadas mixosporas, las cuales son más resistentes a la desecación y, en general, a condiciones ambientales adversas.[62]
Estructura de la célula bacteriana

Las bacterias son organismos relativamente sencillos. Sus dimensiones son muy reducidas, unos 2 μm de ancho por 7-8 μm de longitud en la forma cilíndrica (bacilo) de tamaño medio; aunque son muy frecuentes las especies de 0,5 a 1,5 μm.
Al tratarse de organismos procariotas, tienen las características básicas correspondientes como la carencia de un núcleo delimitado por una membrana, aunque presentan un nucleoide, una estructura elemental que contiene una gran molécula circular de ADN. El citoplasma carece de orgánulos delimitados por membranas y formaciones protoplasmáticas propias de las células eucariotas. En el citoplasma se pueden apreciar plásmidos, pequeñas moléculas circulares de ADN que coexisten con el nucleoide, contienen genes y son comúnmente usados por los procariotas en la conjugación. El citoplasma también contiene vacuolas (gránulos que contienen sustancias de reserva) y ribosomas (utilizados en la síntesis de las proteínas).
Una membrana citoplasmática compuesta de lípidos rodea el citoplasma y, al igual que las células de las plantas, la mayoría posee una pared celular, que en este caso está compuesta por peptidoglicano (mureína). La mayoría de bacterias, presentan además una segunda membrana lipídica (membrana externa) rodeando a la pared celular. El espacio comprendido entre la membrana citoplasmática y la pared celular (o la membrana externa si esta existe) se denomina espacio periplásmico. Algunas bacterias presentan una cápsula y otras son capaces de desarrollarse como endosporas, estados latentes capaces de resistir condiciones extremas. Entre las formaciones exteriores propias de la célula bacteriana destacan los flagelos y los pili.
Estructuras intracelulares

La membrana citoplasmática bacteriana tiene una estructura similar a la de plantas y animales. Es una bicapa lipídica compuesta fundamentalmente de fosfolípidos en la que se insertan moléculas de proteínas. En las bacterias realiza numerosas funciones entre las que se incluyen las de barrera osmótica, transporte, biosíntesis, transducción de energía, centro de replicación de ADN y punto de anclaje para los flagelos. A diferencia de las membranas eucarióticas, generalmente no contiene esteroles (son excepciones micoplasmas y algunas proteobacterias), aunque puede contener componentes similares denominados hopanoides.
Muchas importantes reacciones bioquímicas que tienen lugar en las células se producen por la existencia de gradientes de concentración a ambos lados de una membrana. Este gradiente crea una diferencia de potencial análoga a la de una batería eléctrica y permite a la célula, por ejemplo, el transporte de electrones y la obtención de energía. La ausencia de membranas internas en las bacterias significa que estas reacciones tienen que producirse a través de la propia membrana citoplasmática, entre el citoplasma y el espacio periplásmico.[63]
Puesto que las bacterias son procariotas no tienen orgánulos citoplasmáticos delimitados por membranas y por parecen presentar pocas estructuras intracelulares. Carecen de núcleo celular, mitocondrias, cloroplastos y de los otros orgánulos presentes en las células eucariotas, tales como el aparato de Golgi y el retículo endoplasmático.[64] Algunas bacterias contienen estructuras intracelulares rodeadas por membranas que pueden considerarse primitivos orgánulos, son llamados compartimentos procariotas. Ejemplos son los tilacoides de las cianobacterias, los compartimentos que contienen amonio monooxigenasa en Nitrosomonadaceae y diversas estructuras en Planctomycetota.[65]
Como todos los organismos vivos, las bacterias contienen ribosomas para la síntesis de proteínas, pero estos son diferentes a los de eucariotas.[66] La estructura de los ribosomas y el ARN ribosómico de arqueas y bacterias son similares, ambos ribosomas son de tipo 70S mientras que los ribosomas eucariotas son de tipo 80S. Sin embargo, la mayoría de las proteínas ribosomiales, factores de traducción y ARNt arqueanos son más parecidos a los eucarióticos que a los bacterianos.
Muchas bacterias presentan vacuolas, gránulos intracelulares para el almacenaje de sustancias, como por ejemplo glucógeno,[67] polifosfatos,[68] azufre[69] o polihidroxialcanoatos.[70] Ciertas especies bacterianas fotosintéticas, tales como las cianobacterias, producen vesículas internas de gas que utilizan para regular su flotabilidad y así alcanzar la profundidad con intensidad de luz óptima o unos niveles de nutrientes óptimos.[71] Otras estructuras presentes en ciertas especies son los carboxisomas (que contienen enzimas para la fijación de carbono) y los magnetosomas (para la orientación magnética).

Las bacterias no tienen un núcleo delimitado por membranas. El material genético está organizado en un único cromosoma situado en el citoplasma, dentro de un cuerpo irregular denominado nucleoide.[73] La mayoría de los cromosomas bacterianos son circulares, si bien existen algunos ejemplos de cromosomas lineales, por ejemplo, Borrelia burgdorferi. El nucleoide contiene el cromosoma junto con las proteínas asociadas y ARN. El orden Planctomycetota es una excepción, pues una membrana rodea su nucleoide y tiene varias estructuras celulares delimitadas por membranas.[65]
Anteriormente se pensaba que las células procariotas no poseían citoesqueleto, pero desde entonces se han encontrado homólogos bacterianos de las principales proteínas del citoesqueleto de las eucariotas.[74] Estos incluyen las proteínas estructurales FtsZ (que se ensambla en un anillo para mediar durante la división celular bacteriana) y MreB (que determina la anchura de la célula). El citoesqueleto bacteriano desempeña funciones esenciales en la protección, determinación de la forma de la célula bacteriana y en la división celular.[75]
Estructuras extracelulares
Las bacterias disponen de una pared celular que rodea a su membrana citoplasmática. Las paredes celulares bacterianas están hechas de peptidoglicano (llamado antiguamente mureína). Esta sustancia está compuesta por cadenas de polisacáridos enlazadas por péptidos inusuales que contienen aminoácidos D.[76] Estos aminoácidos no se encuentran en las proteínas, por lo que protegen a la pared de la mayoría de las peptidasas. Las paredes celulares bacterianas son distintas de las que tienen plantas y hongos, compuestas de celulosa y quitina, respectivamente.[77] Son también distintas a las paredes celulares de Archaea, que no contienen peptidoglicano. El antibiótico penicilina puede matar a muchas bacterias inhibiendo un paso de la síntesis del peptidoglicano.[77]

Existen dos diferentes tipos de pared celular bacteriana denominadas Gram-positiva y Gram-negativa. Estos nombres provienen de la reacción de la pared celular a la tinción de Gram, un método tradicionalmente empleado para la clasificación de las especies bacterianas.[78] Las bacterias Gram-positivas tienen una pared celular gruesa que contiene numerosas capas de peptidoglicano en las que se inserta ácido teicoico. En cambio, las bacterias Gram-negativas tienen una pared relativamente fina, consistente en unas pocas capas de peptidoglicano, rodeada por una segunda membrana lipídica (la membrana externa) que contiene lipopolisacáridos y lipoproteínas.
Las micoplasmas son una excepción, pues carecen de pared celular. La mayoría de las bacterias tienen paredes celulares Gram-negativas; solamente son Gram-positivas Bacillota y Actinomycetota. Estos dos grupos eran antiguamente conocidos como bacterias Gram-positivas de contenido GC bajo y bacterias Gram-positivas de contenido GC alto, respectivamente.[79] Estas diferencias en la estructura de la pared celular dan lugar a diferencias en la susceptibilidad antibiótica. Por ejemplo, la vancomicina puede matar solamente a bacterias Gram-positivas y es ineficaz contra patógenos Gram-negativos, tales como Haemophilus influenzae o Pseudomonas aeruginosa.[80] Dentro del filo Actinomycetota cabe hacer una mención especial al género Mycobacterium, el cual, si bien se encuadra dentro de las Gram positivas, no parece serlo desde el punto de vista empírico, ya que su pared no retiene el tinte. Esto se debe a que presentan una pared celular poco común, rica en ácidos micólicos, de carácter hidrófobo y ceroso y bastante gruesa, lo que les confiere una gran resistencia.

Muchas bacterias tienen una capa S de moléculas de proteína de estructura rígida que cubre la pared celular.[81] Esta capa proporciona protección química y física para la superficie celular y puede actuar como una barrera de difusión macromolecular. Las capas S tienen diversas (aunque todavía no bien comprendidas) funciones. Por ejemplo, en el género Campylobacter actúan como factores de virulencia y en la especie Bacillus stearothermophilus contienen enzimas superficiales.[82]
Los flagelos son largos apéndices filamentosos compuestos de proteínas y utilizados para el movimiento. Tienen un diámetro aproximado de 20 nm y una longitud de hasta 20 μm. Los flagelos son impulsados por la energía obtenida de la transferencia de iones. Esta transferencia es impulsada por el gradiente electroquímico que existe entre ambos lados de la membrana citoplasmática.[83]

Las fimbrias son filamentos finos de proteínas que se distribuyen sobre la superficie de la célula. Tienen un diámetro aproximado de 2-10 nm y una longitud de hasta varios μm. Cuando se observan a través del microscopio electrónico se asemejan a pelos finos. Las fimbrias ayudan a la adherencia de las bacterias a las superficies sólidas o a otras células y son esenciales en la virulencia de algunos patógenos.[84] Los pili son apéndices celulares ligeramente mayores que las fimbrias y se utilizan para la transferencia de material genético entre bacterias en un proceso denominado conjugación bacteriana.[85]

Muchas bacterias son capaces de acumular material en el exterior para recubrir su superficie. Dependiendo de la rigidez y su relación con la célula se clasifican en cápsulas y glicocalix. La cápsula es una estructura rígida que se une firmemente a la superficie bacteriana, en tanto que el glicocalix es flexible y se une de forma laxa. Estas estructuras protegen a las bacterias pues dificultan que sean fagocitadas por células eucariotas tales como los macrófagos.[86] También pueden actuar como antígenos y estar implicadas en el reconocimiento bacteriano, así como ayudar a la adherencia superficial y a la formación de biopelículas.[87]
La formación de estas estructuras extracelulares depende del sistema de secreción bacteriano. Este sistema transfiere proteínas desde el citoplasma al periplasma o al espacio que rodea a la célula. Se conocen muchos tipos de sistemas de secreción, que son a menudo esenciales para la virulencia de los patógenos, por lo que son extensamente estudiados.[88]
Endosporas
- Véase también: Esporas bacterianas

Ciertos géneros de bacterias Gram-positivas, tales como Bacillus, Clostridium, Sporohalobacter, Anaerobacter y Heliobacterium, pueden formar endosporas.[89] Las endosporas son estructuras durmientes altamente resistentes cuya función primaria es sobrevivir cuando las condiciones ambientales son adversas. En casi todos los casos, las endosporas no forman parte de un proceso reproductivo, aunque Anaerobacter puede formar hasta siete endosporas a partir de una célula.[90] Las endosporas tienen una base central de citoplasma que contiene ADN y ribosomas, rodeada por una corteza y protegida por una cubierta impermeable y rígida.
Las endosporas no presentan un metabolismo detectable y pueden sobrevivir a condiciones físicas y químicas extremas, tales como altos niveles de luz ultravioleta, rayos gamma, detergentes, desinfectantes, calor, presión y desecación.[91] En este estado durmiente, las bacterias pueden seguir viviendo durante millones de años,[92][93] e incluso pueden sobrevivir en la radiación y vacío del espacio exterior.[94] Las endosporas pueden también causar enfermedades. Por ejemplo, puede contraerse carbunco por la inhalación de endosporas de Bacillus anthracis y tétanos por la contaminación de las heridas con endosporas de Clostridium tetani.[95]
Metabolismo

En contraste con los organismos superiores, las bacterias exhiben una gran variedad de tipos metabólicos.[96] La distribución de estos tipos metabólicos dentro de un grupo de bacterias se ha utilizado tradicionalmente para definir su taxonomía, pero estos rasgos no corresponden a menudo con las clasificaciones genéticas modernas.[97] El metabolismo bacteriano se clasifica con base en tres criterios importantes: el origen del carbono, la fuente de energía y los donadores de electrones. Un criterio adicional para clasificar a los microorganismos que respiran es el receptor de electrones usado en la respiración.[98]
Según la fuente de carbono, las bacterias se pueden clasificar como:
- Heterótrofas, cuando usan compuestos orgánicos.
- Autótrofas, cuando el carbono celular se obtiene mediante la fijación del dióxido de carbono.
Las bacterias autótrofas típicas son las cianobacterias fotosintéticas, las bacterias verdes del azufre y algunas bacterias púrpura. Pero hay también muchas otras especies quimiolitotrofas, por ejemplo, las bacterias nitrificantes y oxidantes del azufre.[99]
Según la fuente de energía, las bacterias pueden ser:
- Fototrofas, cuando emplean la luz a través de la fotosíntesis.
- Quimiotrofas, cuando obtienen energía a partir de sustancias químicas que son oxidadas principalmente a expensas del oxígeno (respiración aerobia) o de otros receptores de electrones alternativos (respiración anaerobia).
Según los donadores de electrones, las bacterias también se pueden clasificar como:
- Litotrofas, si utilizan como donadores de electrones compuestos inorgánicos.
- Organotrofas, si utilizan como donadores de electrones compuestos orgánicos.
Los organismos quimiotrofos usan donadores de electrones para la conservación de energía (durante la respiración aerobia, anaerobia y la fermentación) y para las reacciones biosintéticas (por ejemplo, para la fijación del dióxido de carbono), mientras que los organismos fototrofos los utilizan únicamente con propósitos biosintéticos.

Los organismos que respiran usan compuestos químicos como fuente de energía, tomando electrones del sustrato reducido y transfiriéndolos a un receptor terminal de electrones en una reacción redox. Esta reacción desprende energía que se puede utilizar para sintetizar ATP y así mantener activo el metabolismo. En los organismos aerobios, el oxígeno se utiliza como receptor de electrones. En los organismos anaerobios se utilizan como receptores de electrones otros compuestos inorgánicos tales como nitratos, sulfatos o dióxido de carbono. Esto conduce a que se lleven a cabo los importantes procesos biogeoquímicos de la desnitrificación, la reducción del sulfato y la acetogénesis, respectivamente. Otra posibilidad es la fermentación, un proceso de oxidación incompleta, totalmente anaeróbico, siendo el producto final un compuesto orgánico, que al reducirse será el receptor final de los electrones. Ejemplos de productos de fermentación reducidos son el lactato (en la fermentación láctica), etanol (en la fermentación alcohólica), hidrógeno, butirato, etc. La fermentación es posible porque el contenido de energía de los sustratos es mayor que el de los productos, lo que permite que los organismos sinteticen ATP y mantengan activo su metabolismo.[100][101] Los organismos anaerobios facultativos pueden elegir entre la fermentación y diversos receptores terminales de electrones dependiendo de las condiciones ambientales en las cuales se encuentren.
Las bacterias litotrofas pueden utilizar compuestos inorgánicos como fuente de energía. Los donadores de electrones inorgánicos más comunes son el hidrógeno, el monóxido de carbono, el amoniaco (que conduce a la nitrificación), el hierro ferroso y otros iones de metales reducidos, así como varios compuestos de azufre reducidos. En determinadas ocasiones, las bacterias metanotrofas pueden usar gas metano como fuente de electrones y como sustrato simultáneamente, para el anabolismo del carbono.[102] En la fototrofía y quimiolitotrofía aerobias, se utiliza el oxígeno como receptor terminal de electrones, mientras que bajo condiciones anaeróbicas se utilizan compuestos inorgánicos. La mayoría de los organismos litotrofos son autótrofos, mientras que los organismos organotrofos son heterótrofos.
Además de la fijación del dióxido de carbono mediante la fotosíntesis, algunas bacterias también fijan el gas nitrógeno usando la enzima nitrogenasa. Esta característica es muy importante a nivel ambiental y se puede encontrar en bacterias de casi todos los tipos metabólicos enumerados anteriormente, aunque no es universal.[103] El metabolismo microbiano puede desempeñar un papel importante en la biorremediación pues, por ejemplo, algunas especies pueden realizar el tratamiento de las aguas residuales y otras son capaces de degradar los hidrocarburos, sustancias tóxicas e incluso radiactivas. En cambio, las bacterias reductoras de sulfato son en gran parte responsables de la producción de formas altamente tóxicas de mercurio (metil- y dimetil-mercurio) en el ambiente.[104]
Movimiento

Algunas bacterias son inmóviles y otras limitan su movimiento a cambios de profundidad. Por ejemplo, cianobacterias y bacterias verdes del azufre contienen vesículas de gas con las que pueden controlar su flotabilidad y así conseguir un óptimo de luz y alimento.[105] Las bacterias móviles pueden desplazarse por deslizamiento, mediante contracciones o más comúnmente usando flagelos. Algunas bacterias pueden deslizarse por superficies sólidas segregando una sustancia viscosa, pero el mecanismo que actúa como propulsor es todavía desconocido. En el movimiento mediante contracciones, la bacteria usa su pilus de tipo IV como gancho de ataque, primero lo extiende, anclándolo y después lo contrae con una fuerza notable (>80 pN).[106]
El flagelo bacteriano es un largo apéndice filamentoso helicoidal propulsado por un motor rotatorio (como una hélice) que puede girar en los dos sentidos. El motor utiliza como energía un gradiente electroquímico a través de la membrana. Los flagelos están compuestos por cerca de 20 proteínas, con aproximadamente otras 30 proteínas para su regulación y coordinación.[105] Hay que tener en cuenta que, dado el tamaño de la bacteria, el agua les resulta muy viscosa y el mecanismo de propulsión debe ser muy potente y eficiente. Los flagelos bacterianos se encuentran tanto en las bacterias Gram-positivas como Gram-negativas y son completamente diferentes de los eucarióticos y, aunque son superficialmente similares a los arqueanos, se consideran no homólogos.

Según el número y disposición de los flagelos en la superficie de la bacteria se distinguen los siguientes tipos: un solo flagelo (monotrico), un flagelo en cada extremo (anfitrico), grupos de flagelos en uno o en los dos extremos (lofotrico) y flagelos distribuidos sobre toda la superficie de la célula (peritricos). En un grupo único de bacterias, las espiroquetas, se presentan unos flagelos especializados, denominados filamentos axiales, localizados intracelularmente en el espacio periplásmico, entre las dos membranas. Estos producen un movimiento rotatorio que hace que la bacteria gire como un sacacorchos desplazándose hacia delante.[105]
Muchas bacterias (tales como E. coli) tienen dos tipos de movimiento: en línea recta (carrera) y aleatorio. En este último, se realiza un movimiento tridimensional aleatorio al combinar la bacteria carreras cortas con virajes al azar.[107] Las bacterias móviles pueden presentar movimientos de atracción o repulsión determinados por diferentes estímulos. Estos comportamientos son denominados taxis, e incluyen diversos tipos como la quimiotaxis, la fototaxis o la magnetotaxis.[108][109] En el peculiar grupo de las mixobacterias, las células individuales se mueven juntas formando ondas de células, que terminarán agregándose para formar los cuerpos fructíferos característicos de este género.[110] El movimiento de las mixobacterias se produce solamente sobre superficies sólidas, en contraste con E. coli, que es móvil tanto en medios líquidos como sólidos.
Varias especies de Listeria y Shigella se mueven dentro de las células huésped apropiándose de su citoesqueleto, que normalmente movería los orgánulos. La polimerización de actina crea un empuje en un extremo de la bacteria que la mueve a través del citoplasma de la célula huésped.[111]
Los mecanismos de movimiento bacteriano descritos detallan el modo en que las bacterias se desplazan espacialmente a escala microscópica. El movimiento de bacterias a mayor escala se suele denominar "dispersión" y depende de mecanismos pasivos. En el medio aéreo, las bacterias se transmiten adheridas a partículas de mayor tamaño. Estudios previos muestran como la mayor parte de las bacterias se encuentran en la fracción del aire que contiene las partículas con tamaño superior a 10µm, estos trabajos muestran un mecanismo mediante el que el polen podría ser el principal vector bacteriano a través del aire.[112]
Reproducción

En las bacterias, el aumento en el tamaño de las células (crecimiento) y la reproducción por división celular están íntimamente ligados, como en la mayor parte de los organismos unicelulares. Ocurre por duplicación y se obtienen células con información hereditaria idéntica.[113] Las bacterias crecen hasta un tamaño fijo y después se reproducen por fisión binaria, una forma de reproducción asexual.[114] En condiciones apropiadas, una bacteria Gram-positiva puede dividirse cada 20–30 minutos y una Gram-negativa cada 15–20 minutos, y en alrededor de 16 horas su número puede ascender a unos 5000 millones (cerca del número de personas que habitan la Tierra, que son aproximadamente 7000 millones de personas). Bajo condiciones óptimas, algunas bacterias pueden crecer y dividirse muy rápido, tanto como cada 9,8 minutos.[115] En la división celular se producen dos células hijas idénticas. Algunas bacterias, todavía reproduciéndose asexualmente, forman estructuras reproductivas más complejas que facilitan la dispersión de las células hijas recién formadas. Ejemplos incluyen la formación de cuerpos fructíferos (esporangios) en las mixobacterias, la formación de hifas en Streptomyces y la gemación. En la gemación una célula forma una protuberancia que a continuación se separa y produce una nueva célula hija.
Por otro lado, cabe destacar un tipo de reproducción sexual en bacterias, denominada parasexualidad bacteriana. En este caso, las bacterias son capaces de intercambiar material genético en un proceso conocido como conjugación bacteriana. Durante el proceso una bacteria donante y una bacteria receptora llevan a cabo un contacto mediante pelos sexuales huecos o pili, a través de los cuales se transfiere una pequeña cantidad de ADN independiente o plásmido conjugativo. El mejor conocido es el plásmido F de E. coli, que además puede integrarse en el cromosoma bacteriano. En este caso recibe el nombre de episoma, y en la transferencia arrastra parte del cromosoma bacteriano. Se requiere que exista síntesis de ADN para que se produzca la conjugación. La replicación se realiza al mismo tiempo que la transferencia.
Crecimiento

El crecimiento bacteriano sigue tres fases. Cuando una población bacteriana se encuentra en un nuevo ambiente con elevada concentración de nutrientes que le permiten crecer necesita un período de adaptación a dicho ambiente. Esta primera fase se denomina fase de adaptación o fase lag y conlleva un lento crecimiento, donde las células se preparan para comenzar un rápido crecimiento, y una elevada tasa de biosíntesis de las proteínas necesarias para ello, como ribosomas, proteínas de membrana, etc.[116] La segunda fase de crecimiento se denomina fase exponencial, ya que se caracteriza por el crecimiento exponencial de las células. La velocidad de crecimiento durante esta fase se conoce como la tasa de crecimiento k y el tiempo que tarda cada célula en dividirse como el tiempo de generación g. Durante esta fase, los nutrientes son metabolizados a la máxima velocidad posible, hasta que dichos nutrientes se agoten, dando paso a la siguiente fase. La última fase de crecimiento se denomina fase estacionaria y se produce como consecuencia del agotamiento de los nutrientes en el medio. En esta fase las células reducen drásticamente su actividad metabólica y comienzan a utilizar como fuente energética aquellas proteínas celulares no esenciales. La fase estacionaria es un período de transición desde el rápido crecimiento a un estado de respuesta a estrés, en el cual se activa la expresión de genes involucrados en la reparación del ADN, en el metabolismo antioxidante y en el transporte de nutrientes.[117]
Genética

La mayoría de las bacterias tienen un único cromosoma circular cuyo tamaño puede ir desde solo 160.000 pares de bases en la bacteria endosimbionte Candidatus Carsonella ruddii[118] a los 12.200.000 pares de bases de la bacteria del suelo Sorangium cellulosum.[119] Las espiroquetas del género Borrelia (que incluyen, por ejemplo, a Borrelia burgdorferi, la causa de la enfermedad de Lyme) son una notable excepción a esta regla pues contienen un cromosoma lineal.[120] Las bacterias pueden tener también plásmidos, pequeñas moléculas de ADN extra-cromosómico que pueden contener genes responsables de la resistencia a los antibióticos o factores de virulencia. Otro tipo de ADN bacteriano proviene de la integración de material genético procedente de bacteriófagos (los virus que infectan bacterias). Existen muchos tipos de bacteriófagos, algunos simplemente infectan y rompen las células huésped bacterianas, mientras que otros se insertan en el cromosoma bacteriano. De esta forma se pueden insertar genes del virus que contribuyan al fenotipo de la bacteria. Por ejemplo, en la evolución de Escherichia coli O157:H7 y Clostridium botulinum, los genes tóxicos aportados por un bacteriófago convirtieron a una inofensiva bacteria ancestral en un patógeno letal.[121][122]

Las bacterias, como organismos asexuales que son, heredan copias idénticas de genes, es decir, son clones. Sin embargo, pueden evolucionar por selección natural mediante cambios en el ADN debidos a mutaciones y a la recombinación genética. Las mutaciones provienen de errores durante la réplica del ADN o por exposición a agentes mutagénicos. Las tasas de mutación varían ampliamente entre las diversas especies de bacterias e incluso entre diferentes cepas de una misma especie de bacteria.[123] Los cambios genéticos pueden producirse al azar o ser seleccionados por estrés, en donde los genes implicados en algún proceso que limita el crecimiento tienen una mayor tasa de mutación.[124]
Las bacterias también pueden transferirse material genético entre células. Esto puede realizarse de tres formas principalmente. En primer lugar, las bacterias pueden recoger ADN exógeno del ambiente en un proceso denominado transformación. Los genes también se pueden transferir por un proceso de transducción mediante el cual un bacteriófago introduce ADN extraño en el cromosoma bacteriano. El tercer método de transferencia de genes es por conjugación bacteriana, en donde el ADN se transfiere a través del contacto directo (por medio de un pilus) entre células. Esta adquisición de genes de otras bacterias o del ambiente se denomina transferencia de genes horizontal y puede ser común en condiciones naturales[125] La transferencia de genes es especialmente importante en la resistencia a los antibióticos, pues permite una rápida diseminación de los genes responsables de dicha resistencia entre diferentes patógenos.[126]
Interacciones con otros organismos
A pesar de su aparente simplicidad, las bacterias pueden formar asociaciones complejas con otros organismos. Estas asociaciones se pueden clasificar como parasitismo, mutualismo y comensalismo.
Comensales
Debido a su pequeño tamaño, las bacterias comensales son ubicuas y crecen sobre animales y plantas exactamente igual a como crecerían sobre cualquier otra superficie. Así, por ejemplo, grandes poblaciones de estos organismos son las causantes del mal olor corporal y su crecimiento puede verse aumentado con el calor y el sudor.
Mutualistas
Ciertas bacterias forman asociaciones íntimas con otros organismos, que les son imprescindibles para su supervivencia. Una de estas asociaciones mutualistas es la transferencia de hidrógeno entre especies. Se produce entre grupos de bacterias anaerobias que consumen ácidos orgánicos tales como ácido butírico o ácido propiónico y producen hidrógeno, y las arqueas metanógenas que consumen dicho hidrógeno.[127] Las bacterias en esta asociación no pueden consumir los ácidos orgánicos cuando el hidrógeno se acumula a su alrededor. Solamente la asociación íntima con las arqueas mantiene una concentración de hidrógeno lo bastante baja para permitir que las bacterias crezcan.
En el suelo, los microorganismos que habitan la rizosfera (la zona que incluye la superficie de la raíz y la tierra que se adhiere a ella) realizan la fijación de nitrógeno, convirtiendo el nitrógeno atmosférico (en estado gaseoso) en compuestos nitrogenados.[128] Esto proporciona a muchas plantas, que no pueden fijar el nitrógeno por sí mismas, una forma fácilmente absorbible de nitrógeno.
Muchas otras bacterias se encuentran como simbiontes en seres humanos y en otros organismos. Por ejemplo, en el tracto digestivo proliferan unas mil especies bacterianas. Sintetizan vitaminas tales como ácido fólico, vitamina K y biotina. También fermentan los carbohidratos complejos indigeribles y convierten los azúcares de la leche en ácido láctico (por ejemplo, Lactobacillus).[129][130][131][132] Además, la presencia de esta flora intestinal inhibe el crecimiento de bacterias potencialmente patógenas (generalmente por exclusión competitiva). Muchas veces estas bacterias beneficiosas se venden como suplementos dietéticos probióticos.[133]
Patógenos

Solo una pequeña fracción de las bacterias causan enfermedades en los seres humanos: de las 15.919 especies registradas en la base de datos de NCBI, solo 538 son patógenas.[134] Aun así son una de las principales causas de enfermedad y mortalidad humana, causando infecciones tales como el tétanos, la fiebre tifoidea, la difteria, la sífilis, el cólera, intoxicaciones alimentarias, la lepra y la tuberculosis. Hay casos en los que la etiología o causa de una enfermedad conocida se descubre solamente después de muchos años, como fue el caso de la úlcera péptica y Helicobacter pylori. Las enfermedades bacterianas son también importantes en la agricultura y en la ganadería, donde existen multitud de enfermedades como por ejemplo la mancha de la hoja, la plaga de fuego, la paratuberculosis, el añublo bacterial de la panícula, la mastitis, la salmonela y el carbunco.
Cada especie de patógeno tiene un espectro característico de interacciones con sus huéspedes humanos. Algunos organismos, tales como Staphylococcus o Streptococcus, pueden causar infecciones de la piel, pulmonía, meningitis e incluso sepsis, una respuesta inflamatoria sistémica que produce shock, vasodilatación masiva y muerte.[135] Sin embargo, estos organismos son también parte de la flora humana normal y se encuentran generalmente en la piel o en la nariz sin causar ninguna enfermedad.
Otros organismos causan invariablemente enfermedades en los seres humanos. Por ejemplo, el género Rickettsia, que son parásitos intracelulares obligados capaces de crecer y reproducirse solamente dentro de las células de otros organismos. Una especie de Rickettsia causa el tifus, mientras que otra ocasiona la fiebre de las Montañas Rocosas. Chlamydiae, otro filo de parásitos obligados intracelulares, contiene especies que causan neumonía, infecciones urinarias y pueden estar implicadas en la enfermedad coronaria.[136] Finalmente, ciertas especies tales como Pseudomonas aeruginosa, Burkholderia cenocepacia y Mycobacterium avium son patógenos oportunistas y causan enfermedades principalmente en las personas que sufren inmunosupresión o fibrosis quística.[137][138]
Las infecciones bacterianas se pueden tratar con antibióticos, que se clasifican como bactericidas, si matan bacterias, o como bacterioestáticos, si solo detienen el crecimiento bacteriano. Existen muchos tipos de antibióticos y cada tipo inhibe un proceso que difiere en el patógeno con respecto al huésped. Ejemplos de antibióticos de toxicidad selectiva son el cloranfenicol y la puromicina, que inhiben el ribosoma bacteriano, pero no el ribosoma eucariota que es estructuralmente diferente.[139] Los antibióticos se utilizan para tratar enfermedades humanas y en la ganadería intensiva para promover el crecimiento animal. Esto último puede contribuir al rápido desarrollo de la resistencia antibiótica de las poblaciones bacterianas.[140] Las infecciones se pueden prevenir con medidas antisépticas tales como la esterilización de la piel antes de las inyecciones y con el cuidado apropiado de los catéteres. Los instrumentos quirúrgicos y dentales también son esterilizados para prevenir la contaminación e infección por bacterias. Los desinfectantes tales como la lejía se utilizan para matar bacterias u otros patógenos que se depositan sobre las superficies y así prevenir la contaminación y reducir el riesgo de infección.
La siguiente tabla muestra algunas enfermedades humanas producidas por bacterias:
Clasificación e identificación
La clasificación taxonómica busca describir y diferenciar la amplia diversidad de especies bacterianas poniendo nombres y agrupando organismos según sus similitudes. Las bacterias pueden clasificarse con base en diferentes criterios, como estructura celular, metabolismo o con base en diferencias en determinados componentes como ADN, ácidos grasos, pigmentos, antígenos o quinonas.[141] Sin embargo, aunque estos criterios permitían la identificación y clasificación de cepas bacterianas, aún no quedaba claro si estas diferencias representaban variaciones entre especies diferentes o entre distintas cepas de la misma especie. Esta incertidumbre se debía a la ausencia de estructuras distintivas en la mayoría de las bacterias y a la existencia de la transferencia horizontal de genes entre especies diferentes,[142] la cual da lugar a que bacterias muy relacionadas puedan llegar a presentar morfologías y metabolismos muy diferentes. Por ello, y con el fin de superar esta incertidumbre, la clasificación bacteriana actual se centra en el uso de técnicas moleculares modernas (filogenia molecular), tales como la determinación del contenido de guanina/citosina, la hibridación genoma-genoma o la secuenciación de ADN ribosómico, el cual no se ve involucrado en la transferencia horizontal.[143]
El Comité Internacional de Sistemática de Procariotas (ICSP) es el organismo encargado de la nomenclatura, taxonomía y las normas según las cuales son designados los procariotas.[144] El ICSP es responsable de la publicación del Código Internacional de Nomenclatura de Bacterias (lista de nombres aprobados de especies y taxones bacterianos).[145] También publica la Revista Internacional de Bacteriología Sistemática (International Journal of Systematic Bacteriology).[146] En contraste con la nomenclatura procariótica, no hay una clasificación oficial de los procariotas porque la taxonomía sigue siendo una cuestión de criterio científico. La clasificación más aceptada es la elaborada por la oficina editorial del Manual de Bacteriología Sistemática de Bergey (Bergey's Manual of Systematic Bacteriology) como paso preliminar para organizar el contenido de la publicación.[147] Esta clasificación, conocida como "The Taxonomic Outline of Bacteria and Archaea" (TOBA), está disponible en Internet.[148] Debido a la reciente introducción de la filogenia molecular y del análisis de las secuencias de genomas, la clasificación bacteriana actual es un campo en continuo cambio y plena expansión.[149][150]
La identificación de bacterias en el laboratorio es particularmente relevante en medicina, donde la determinación de la especie causante de una infección es crucial a la hora de aplicar un correcto tratamiento. Por ello, la necesidad de identificar a los patógenos humanos ha dado lugar a un potente desarrollo de técnicas para la identificación de bacterias.

La técnica de tinción de membranas de bacterias de Gram, desarrollada por Hans Christian Gram en 1884,[151] ha supuesto un antes y un después en el campo de la medicina, y consiste en teñir con tintes específicos diversas muestras de bacterias en un portaobjetos para saber si se han teñido o no con dicho tinte.[152]
Una vez se han adicionado los tintes específicos en las muestras, y se ha lavado la muestra pasados unos minutos para evitar confusiones, hay que limpiarlas con unas gotas de alcohol etílico. La función del alcohol es la de eliminar el tinte de las bacterias, y es aquí donde se reconocen las bacterias que se han tomado: si la bacteria conserva el tinte, es una Gram positiva, las cuales poseen una pared más gruesa constituida por varias decenas de capas de diversos componentes proteicos; en el caso de que el tinte no se mantenga, la bacteria es una Gram negativa, la cual posee una pared de una composición diferente. La función biológica que posee esta técnica es la de fabricar antibióticos específicos para esas bacterias.
Esta tinción es empleada en microbiología para la visualización de bacterias en muestras clínicas. También se emplea como primer paso en la distinción de diferentes especies de bacterias,[153] considerándose bacterias Gram positivas a aquellas que se tornan de color violeta y Gram negativas a las que se tornan de color rojo.[154][155]
En el análisis de muestras clínicas suele ser un estudio fundamental por cumplir varias funciones:
- Identificación preliminar de la bacteria causante de la infección.
- Consideración de la calidad de la muestra biológica para el estudio, es decir, permite apreciar el número de células inflamatorias así como de células epiteliales. A mayor número de células inflamatorias en cada campo del microscopio, más probabilidad de que la flora que crezca en los medios de cultivo sea la representativa de la zona infectada. A mayor número de células epiteliales sucede los contrario, mayor probabilidad de contaminación con flora saprofita.
- Utilidad como control de calidad del aislamiento bacteriano. Las cepas bacterianas identificadas en la tinción de Gram se deben corresponder con aislamientos bacterianos realizados en los cultivos. Si se observan mayor número de formas bacterianas que las aisladas, entonces hay que reconsiderar los medios de cultivos empleados así como la atmósfera de incubación.
Filos y filogenia

Las relaciones filogenéticas de los seres vivos son motivo de controversia y no hay un acuerdo general entre los diferentes autores. La mayoría de árboles filogenéticos, en especial los de ARNr 16S y 23S, muestran que los grupos basales son filos termófilos como Aquificota y Thermotogota,[156] lo que reforzaría el origen termófilo de los dominios Archaea y Bacteria. En cambio, algunos árboles genómicos muestran a Bacillota (Gram positivos) como el clado más antiguo.[157] Según las teorías de Cavalier-Smith la mayor divergencia se encuentra en un grupo fotosintético que denomina Chlorobacteria (Chloroflexi).[43] Otros estudios filogenéticos genómicos o proteicos colocan en una posición basal a Planctomycetota, Pseudomonadota u otros filos. Finalmente se ha propuesto que hubo una temprana divergencia entre dos supergrupos: Gracilicutes y Terrabacteria;[158] demostrando en suma que actualmente no existe un filogenia bacteriana estable como para conocer con certeza la historia evolutiva bacteriana más temprana. Esto debido con toda probabilidad al fenómeno de la transferencia genética horizontal, típica de los organismos procariotas.
Los principales filos bacterianos se pueden organizar dentro de un amplio criterio filogenético en tres conjuntos:
Grupos termófilos

De acuerdo con la mayoría de árboles filogenéticos moleculares, las bacterias termófilas son los más divergentes, formando un grupo parafilético basal, lo que es compatible con las principales teorías sobre el origen y evolución procariota. Son termófilos e hipertermófilos con metabolismo quimiotrofo, respiración anaerobia y estructura Gram negativa (de doble membrana), destacando los siguientes filos:
- Aquificota. Pequeño grupo de bacterias quimiolitotrofas, termófilas o hipertermófilas. Se las encuentra en manantiales calientes, pozos sulfurosos y fuentes hidrotermales oceánicas.
- Thermotogota. Un filo de hipertermófilos, anaerobios obligados, heterótrofos fermentativos.
- Dictyoglomota. Comprende una sola especie de hipertermófilo, quimioorganotrofo y aerobio.
- Thermodesulfobacteriota: Termófilas reductoras de sulfato.
- Caldisericota. Bacteria termófila anaerobia.
- Synergistota. Bacterias anaerobias. Aunque pocos géneros son termófilos, Synergistota tiene posición basal en la filogenia bacteriana del ARNr.
Gram positivos y relacionados

Los grupos Gram positivos son básicamente Bacillota y Actinomycetota, los cuales habría engrosado su pared celular como una adaptación a la desecación con pérdida de la membrana externa, desarrollando esteroles, ácido teicoico y formando esporas en varios grupos. El término Posibacteria se ha usado como taxón para agrupar a los Gram positivos y grupos derivados como Tenericutes. El término monodérmico alude a la única membrana celular que poseen los Gram positivos, lo que significa que otros filos como Chloroflexota y Thermomicrobia, al ser monodérmicos, están relacionados con los primeros a pesar de que son Gram variables. Según algunos árboles filogenéticos, los filos monodérmicos forman parte de un superclado denominado Terrabacteria, llamados así por su probable evolución en medios terrestres, y se incluye en él a filos didérmicos como Deinococcota que es Gram variable y al grupo Cyanobacteria/Melainabacteria que es Gram negativo. Los Gram positivos y relacionados (Terrabacteria) se presentan en la mayoría de árboles filogenéticos como un grupo parafilético con respecto a Gracilicutes y está conformado por los siguientes filos:
- Actinomycetota. Un extenso filo de bacterias Gram positivas de contenido GC alto. Son comunes en el suelo aunque algunas habitan en plantas y animales, incluyendo algunos patógenos. Algunas forman colonias en forma de hifas (Actinomyces).
- Bacillota o Endobacteria. Es el grupo más extenso y comprende a las bacterias Gram positivas con contenido GC bajo. Se encuentran en diversos hábitats, incluyendo algunos patógenos notables. Una de las familias, Heliobacteria, obtiene su energía a través de la fotosíntesis y otros tienen una pseudo membrana externa (Negativicutes).
- Tenericutes o Mollicutes. Son endosimbiontes Gram negativos monodérmicos y sin pared celular. Se derivan de Bacillota según la mayoría de filogenias.
- Deinococcota o Hadobacteria. Pequeño grupo de quimiorganotrofos extremófilos altamente resistentes. Unas especies soportan el calor y el frío extremo, mientras que otras son resistentes a la radiación y a las sustancias tóxicas.
- Chloroflexota. Pequeño filo de bacterias monodérmicas Gram variables aerobias facultativas y típicamente filamentosas. Incluye a las bacterias verdes no del azufre, las cuales realizan la fotosíntesis anoxigénica mediante bacterioclorofila (sin producción de oxígeno) y en donde su vía de fijación del carbono también difiere de la de otras bacterias fotosintéticas.
- Thermomicrobia. Pequeño filo (o clase) termófilo derivado de Chloroflexota.
- Cyanobacteriota (algas verde-azuladas). El grupo más importante de bacterias fotosintéticas. Presentan clorofila y realizan la fotosíntesis oxigénica. Son unicelulares o coloniales filamentosas.
- Armatimonadota. Pequeño grupo aerobio quimioheterótrofo.
Gracilicutes

El superclado Gracilicutes o Hydrobacteria está bien consensuado en muchos árboles filogenéticos. Son el mayor grupo de bacterias Gram negativas, didérmicas, en su mayoría quimioheterótrofas, de hábitat acuático o relacionado con animales y plantas como comensal, mutualista o patógeno. Está conformado por varios filos y superfilos:
- Spirochaetota. Bacterias quimioheterótrofas con forma alargada típicamente enrollada en espiral que se desplazan mediante rotación. Muchas producen enfermedades.
- Grupo FCB o Sphingobacteria.
- Fibrobacterota. Pequeño filo de que incluye muchas de las bacterias estomacales que permiten la degradación de la celulosa en los rumiantes.
- Gemmatimonadota. Aerobios del suelo y el fango.
- Bacteroidota. Un extenso filo de bacterias con amplia distribución en el medio ambiente, incluyendo el suelo, sedimentos, agua de mar y el tracto digestivo de los animales. Es un grupo heterogéneo que incluye aerobios obligados o anaerobios obligados, comensales, parásitos y formas de vida libre.
- Chlorobia. Destacan las bacterias verdes del azufre, las cuales son fototrofas mediante bacterioclorofila y anaerobias obligadas. Algunas son termófilas que viven en fuentes hidrotermales. Se consideran derivados o relacionados con Bacteroidetes a nivel de filo.
- Grupo PVC o Planctobacteria
- Planctomycetota. Bacterias principalmente acuáticas aerobias encontradas en agua dulce, salobre y marina. Su ciclo biológico implica la alternancia entre células sésiles y flageladas. Se reproducen por gemación.
- Verrucomicrobiota. Comprende bacterias terrestres, acuáticas y algunas asociadas con huéspedes eucariotas.
- Lentisphaerae. Pequeño grupo de bacterias recientemente descubiertas en aguas marinas y hábitats terrestres anaerobios. Se consideran derivados o relacionados con Verrucomicrobia a nivel de filo.
- Chlamydiota. Un pequeño grupo de parásitos intracelulares obligados de las células eucariotas.
- Elusimicrobiota. Se encuentra disperso por mar, tierra y como endosimbionte de insectos.
- Pseudomonadota (bacterias púrpuras y relacionadas). Es un grupo muy diverso y extenso. La mayoría son heterótrofas, otras son fermentadoras como las enterobacterias y muchas causan enfermedades como las ricketsias que son parásitos intracelulares. Los rizobios son endosimbiontes fijadores de nitrógeno en las plantas, las bacterias púrpuras son fototrofas con bacterioclorofila y las mixobacterias forman agregados multicelulares. Algunos autores consideran que son derivados o relacionados con Proteobacteria los siguientes filos:
- Acidobacteriota. Pequeño filo de bacterias acidófilas comunes en el suelo. Incluye una bacteria fototrofa usando bacterioclorofila.
- Deferribacterota. Pequeño grupo de bacterias acuáticas anaerobias.
- Chrysiogenota. Pequeño grupo quimiolitoautótrofo anaerobio con una bioquímica y una forma de vida únicas, capaces de respirar arseniato.
- Nitrospirota. Grupo de quimiosintéticos oxidantes de nitrógeno y algunos son termófilos.
- Fusobacteriota. No siempre se le incluye en Gracilicutes. Son bacterias heterótrofas anaerobias causantes de infecciones en humanos. Constituyen uno de los principales tipos de flora del aparato digestivo.
Grupo CPR y otros filos candidatos
Recientemente, los análisis genómicos de las muestras tomadas del medio ambiente han identificado un gran número de filos candidatos de bacterias ultrapequeñas, cuyos representantes todavía no han sido cultivados. Estas bacterias no habían sido detectadas por los procedimientos tradicionales debido a sus especiales características metabólicas. A modo de ejemplo, una nueva línea filogenética de bacterias conteniendo 35 filos, el grupo CPR, ha sido recientemente identificado. De esta forma, el número de filos del dominio Bacteria se amplía hasta casi 100 y supera ampliamente en diversidad a los organismos de los otros dos dominios.[5][159] Sin embargo, En 2018 en una revisión taxonómica para estandarizar la taxonomía bacteriana se encontró que CPR o Patescibacteria comprende un único filo con varios taxones de rango inferior, en vez de una radiación de múltiples filos.[160]
Uso de las bacterias en la tecnología y la industria
Muchas industrias dependen en parte o enteramente de la acción bacteriana. Gran cantidad de sustancias químicas importantes como alcohol etílico, ácido acético, alcohol butílico y acetona son producidas por bacterias específicas. También se emplean bacterias para el curado de tabaco, el curtido de cueros, caucho, algodón, etc. Las bacterias (a menudo Lactobacillus) junto con levaduras y mohos, se han utilizado durante miles de años para la preparación de alimentos fermentados tales como queso, mantequilla, encurtidos, salsa de soja, chucrut, vinagre, vino y yogur.[161][162]
Las bacterias tienen una capacidad notable para degradar una gran variedad de compuestos orgánicos, por lo que se utilizan en el reciclado de basura y en biorremediación. Las bacterias capaces de degradar los hidrocarburos son de uso frecuente en la limpieza de los vertidos de petróleo.[163] Así por ejemplo, después del vertido del petrolero Exxon Valdez en 1989, en algunas playas de Alaska se usaron fertilizantes con objeto de promover el crecimiento de estas bacterias naturales. Estos esfuerzos fueron eficaces en las playas en las que la capa de petróleo no era demasiado espesa. Las bacterias también se utilizan para la biorremediación de basuras tóxicas industriales.[164] En la industria química, las bacterias son utilizadas en la síntesis de productos químicos enantioméricamente puros para uso farmacéutico o agroquímico.[165]
Las bacterias también pueden ser utilizadas para el control biológico de parásitos en sustitución de los pesticidas. Esto implica comúnmente a la especie Bacillus thuringiensis (también llamado BT), una bacteria de suelo Gram-positiva. Las subespecies de esta bacteria se utilizan como insecticidas específicos para lepidópteros.[166] Debido a su especificidad, estos pesticidas se consideran respetuosos con el medio ambiente, con poco o ningún efecto sobre los seres humanos, la fauna y la mayoría de los insectos beneficiosos, como por ejemplo, los polinizadores.[167][168]

Las bacterias son herramientas básicas en los campos de la biología, la genética y la bioquímica moleculares debido a su capacidad para crecer rápidamente y a la facilidad relativa con la que pueden ser manipuladas. Realizando modificaciones en el ADN bacteriano y examinando los fenotipos que resultan, los científicos pueden determinar la función de genes, enzimas y rutas metabólicas, pudiendo trasladar posteriormente estos conocimientos a organismos más complejos.[169] La comprensión de la bioquímica celular, que requiere cantidades enormes de datos relacionados con la cinética enzimática y la expresión de genes, permitirá realizar modelos matemáticos de organismos enteros. Esto es factible en algunas bacterias bien estudiadas. Por ejemplo, actualmente está siendo desarrollado y probado el modelo del metabolismo de Escherichia coli.[170][171] Esta comprensión del metabolismo y la genética bacteriana permite a la biotecnología la modificación de las bacterias para que produzcan diversas proteínas terapéuticas, tales como insulina, factores de crecimiento y anticuerpos.[172][173]
Galería
Véase también
- Bacteriófago
- Bacteriología
- Biotecnología
- Extremófilo
- Microbiología
- Nanobio
- Código Internacional de Nomenclatura de Bacterias
- Categoría:Enfermedades bacterianas
- Microbiota normal
Notas
Referencias
- Dodd, Matthew S.; Papineau, Dominic; Grenne, Tor; Slack, John F.; Rittner, Martin; Pirajno, Franco; O’Neil, Jonathan; Little, Crispin T. S. (2 de marzo de 2017). «Evidence for early life in Earth’s oldest hydrothermal vent precipitates». Nature (en inglés) 543 (7643): 60-64. ISSN 0028-0836. doi:10.1038/nature21377. Consultado el 13 de junio de 2017.
- Woese, C., Kandler, O., Wheelis, M. (1990). «Towards a natural system of organisms: proposal for the domains Archaea, Bacteria, and Eucarya». Proc Natl Acad Sci U S A 87 (12): 4576-9. PMID 2112744. Archivado desde el original el 27 de junio de 2008. Consultado el 6 de abril de 2007.
- Classification of domains and phyla - Hierarchical classification of prokaryotes (bacteria) LPSN, revisado en octubre de 2015.
- Christian Rinke et al 2013. «Insights into the phylogeny and coding potential of microbial dark matter.» Nature, Vol 499, pp. 431-437. 25 de julio de 2013 doi:10.1038/nature12352
- Hug, L. A., Baker, B. J., Anantharaman, K., Brown, C. T., Probst, A. J., Castelle, C. J., ... & Suzuki, Y. (2016). A new view of the tree of life. Nature Microbiology, 1, 16048.
- Totis, Niccolò; Nieto, César; Küper, Armin; Vargas-García, César; Singh, Abhyudai; Waldherr, Steffen (2021-04). «A Population-Based Approach to Study the Effects of Growth and Division Rates on the Dynamics of Cell Size Statistics». IEEE Control Systems Letters 5 (2): 725-730. ISSN 2475-1456. doi:10.1109/LCSYS.2020.3005069. Consultado el 28 de julio de 2022.
- Murray, Patrick R. (2009). Microbiología Médica + Student Consult, 6a ed.. Elsevier España. ISBN 978-84-8086-465-7. Consultado el 26 de noviembre de 2019.
- Fredrickson J, Zachara J, Balkwill D, et al (2004). «Geomicrobiology of high-level nuclear waste-contaminated vadose sediments at the hanford site, Washington state». Appl Environ Microbiol 70 (7): 4230-41. PMID 15240306. Archivado desde el original el 29 de septiembre de 2008. Consultado el 6 de abril de 2007.
- Whitman, W., Coleman, D., Wiebe, W. (1998). «Prokaryotes: the unseen majority». Proc Natl Acad Sci U S A 95 (12): 6578-83. PMID 9618454. Archivado desde el original el 5 de marzo de 2008. Consultado el 6 de abril de 2007.
- Rappé. M., Giovannoni, S. «The uncultured microbial majority». Annu Rev Microbiol 57: 369-94. PMID 14527284.
- Sears C (2005). «A dynamic partnership: Celebrating our gut flora». Anaerobe 11 (5): 247-51. PMID 16701579.
- «Tuberculosis: Key Facts». Organización Mundial de la Salud (en inglés). Consultado el 7 de junio de 2020.
- Ishige, T, Honda, K., Shimizu, S. (2005). «Whole organism biocatalysis». Curr Opin Chem Biol 9 (2): 174-80. PMID 15811802.
- Ibrahim B. Syed, (2002). "Islamic Medicine: 1000 years ahead of its times", Journal of the Islamic Medical Association 2, pp. 2-9.
- Ober WB, Aloush N (1982). «The plague at Granada, 1348-1349: Ibn Al-Khatib and ideas of contagion». Bulletin of the New York Academy of Medicine 58 (4): 418-24. PMID 7052179.
- Beretta M (2003). «The revival of Lucretian atomism and contagious diseases during the renaissance». Medicina nei secoli 15 (2): 129-54. PMID 15309812.
- Porter JR (1976). «Antony van Leeuwenhoek: Tercentenary of his discovery of bacteria». Bacteriological reviews 40 (2): 260-9. PMID 786250. Consultado el 19 de agosto de 2007.
- van Leeuwenhoek A (1684). «An abstract of a letter from Mr. Anthony Leevvenhoek at Delft, dated Sep. 17, 1683, Containing Some Microscopical Observations, about Animals in the Scurf of the Teeth, the Substance Call'd Worms in the Nose, the Cuticula Consisting of Scales». Philosophical Transactions (1683–1775) 14: 568-74. Consultado el 19 de agosto de 2007. (enlace roto disponible en Internet Archive; véase el historial, la primera versión y la última).
- van Leeuwenhoek A (1700). «Part of a Letter from Mr Antony van Leeuwenhoek, concerning the Worms in Sheeps Livers, Gnats, and Animalcula in the Excrements of Frogs». Philosophical Transactions (1683–1775) 22: 509-18. Archivado desde el original el 5 de enero de 2010. Consultado el 19 de agosto de 2007.
- van Leeuwenhoek A (1702). «Part of a Letter from Mr Antony van Leeuwenhoek, F. R. S. concerning Green Weeds Growing in Water, and Some Animalcula Found about Them». Philosophical Transactions (1683–1775) 23: 1304-11. Archivado desde el original el 18 de enero de 2010. Consultado el 19 de agosto de 2007.
- «Etymology of the word "bacteria"». Online Etymology dictionary. Consultado el 23 de noviembre de 2006.
- Jan Sapp 2006, Two faces of the prokaryote concept Archivado el 9 de mayo de 2008 en Wayback Machine. International Microbiology, Canada, 9:163-172
- «Pasteur's Papers on the Germ Theory». LSU Law Center's Medical and Public Health Law Site, Historic Public Health Articles. Consultado el 23 de noviembre de 2006.
- «The Nobel Prize in Physiology or Medicine 1905». Nobelprize.org. Consultado el 22 de noviembre de 2006.
- O'Brien S, Goedert J (1996). «HIV causes AIDS: Koch's postulates fulfilled». Curr Opin Immunol 8 (5): 613-18. PMID 8902385.
- Thurston A (2000). «Of blood, inflammation and gunshot wounds: the history of the control of sepsis». Aust N Z J Surg 70 (12): 855-61. PMID 11167573.
- «Biography of Paul Ehrlich». Nobelprize.org. Consultado el 26 de noviembre de 2006.
- Schwartz R (2004). «Paul Ehrlich's magic bullets». N Engl J Med 350 (11): 1079-80. PMID 15014180.
- Woese C, Fox G (1977). «Phylogenetic structure of the prokaryotic domain: the primary kingdoms». Proc Natl Acad Sci U S A 74 (11): 5088-90. PMID 270744.
- Woese C, Kandler O, Wheelis M (1990). «Towards a natural system of organisms: proposal for the domains Archaea, Bacteria, and Eucarya». Proc Natl Acad Sci U S A 87 (12): 4576-79. PMID 2112744. Archivado desde el original el 27 de junio de 2008. Consultado el 6 de abril de 2007.
- Battistuzzi F, Feijao A, Hedges S. A genomic timescale of prokaryote evolution: insights into the origin of methanogenesis, phototrophy, and the colonization of land. BMC.
- Fabia U. Battistuzzi & S. Blair Hedges 2008. A Major Clade of Prokaryotes with Ancient Adaptations to Life on Land. Oxford Academic.
- Woese C, Kandler O, Wheelis M (1990). «Towards a natural system of organisms: proposal for the domains Archaea, Bacteria, and Eucarya». Proc Natl Acad Sci U S A 87 (12): 4576-9. PMID 2112744. Archivado desde el original el 27 de junio de 2008. Consultado el 6 de abril de 2007.
- Gupta R (2000). «The natural evolutionary relationships among prokaryotes.». Crit Rev Microbiol 26 (2): 111-31. PMID 10890353.
- Schopf J (1994). «Disparate rates, differing fates: tempo and mode of evolution changed from the Precambrian to the Phanerozoic». Proc Natl Acad Sci U S A 91 (15): 6735-42. PMID 8041691.
- DeLong E, Pace N (2001). «Environmental diversity of bacteria and archaea». Syst Biol 50 (4): 470-78. PMID 12116647.
- Brown J, Doolittle W (1997). «Archaea and the prokaryote-to-eukaryote transition». Microbiol Mol Biol Rev 61 (4): 456-502. PMID 9409149.
- Qiyun Zhu, Uyen Mai, Rob Knight. (2019). Phylogenomics of 10,575 genomes reveals evolutionary proximity between domains Bacteria and Archaea. Nature.
- Wang M, Yafremava LS, Caetano-Anollés D, Mittenthal JE, Caetano-Anollés G (2007). «Reductive evolution of architectural repertoires in proteomes and the birth of the tripartite world». Genome Res. 17 (11): 1572-85. PMID 17908824. doi:10.1101/gr.6454307.
- Di Giulio M (2003). «The universal ancestor and the ancestor of bacteria were hyperthermophiles». J Mol Evol 57 (6): 721-30. PMID 14745541.
- Battistuzzi F, Feijao A, Hedges S. «A genomic timescale of prokaryote evolution: insights into the origin of methanogenesis, phototrophy, and the colonization of land.». BMC Evol Biol 4: 44. PMID 15535883.
- Cavalier-Smith T (2006). «Cell evolution and Earth history: stasis and revolution». Philos Trans R Soc Lond B Biol Sci 361 (1470): 969-1006. PMID 16754610. (enlace roto disponible en Internet Archive; véase el historial, la primera versión y la última).
- Thomas Cavalier-Smith (2006), Rooting the tree of life by transition analyses, Biol Direct. 1: 19. doi: 10.1186/1745-6150 de enero de 19.
- T. Cavalier-Smith (2002). «The phagotrophic origin of eukaryotes and phylogenetic classification of Protozoa». International Journal of Systematic and Evolutionary Microbiology 52: 297-354.
- Cavalier-Smith T (2002). «The neomuran origin of archaebacteria, the negibacterial root of the universal tree and bacterial megaclassification.». Int J Syst Evol Microbiol 52 (Pt 1): 7-76. PMID 11837318.
- Poole A, Penny D (2007). «Evaluating hypotheses for the origin of eukaryotes». Bioessays 29 (1): 74-84. PMID 17187354.
- Dyall S, Brown M, Johnson P (2004). «Ancient invasions: from endosymbionts to organelles». Science 304 (5668): 253-7. PMID 15073369.
- Lang B, Gray M, Burger G. «Mitochondrial genome evolution and the origin of eukaryotes». Annu Rev Genet 33: 351-97. PMID 10690412.
- McFadden G (1999). «Endosymbiosis and evolution of the plant cell». Curr Opin Plant Biol 2 (6): 513-9. PMID 10607659.
- Schulz H, Jorgensen B. «Big bacteria». Annu Rev Microbiol 55: 105-37. PMID 11544351.
- Volland, Jean-Marie; Gonzalez-Rizzo, Silvina; Gros, Olivier; Tyml, Tomáš; Ivanova, Natalia; Schulz, Frederik; Goudeau, Danielle; Elisabeth, Nathalie H; Nath, Nandita; Udwary, Daniel; Malmstrom, Rex R; Guidi-Rontani, Chantal; Bolte-Kluge, Susanne; Davies, Karen M; Jean, Maïtena R; Mansot, Jean-Louis; Mouncey, Nigel J; Angert, Esther; Woyke, Tanja; Date, Shailesh V (18 de febrero de 2022), A centimeter-long bacterium with DNA compartmentalized in membrane-bound organelles, Cold Spring Harbor Laboratory, S2CID 246975579, doi:10.1101/2022.02.16.480423.
- Robertson J, Gomersall M, Gill P. (1975). «Mycoplasma hominis: growth, reproduction, and isolation of small viable cells». J Bacteriol. 124 (2): 1007-18. PMID 1102522.
- Fritz I, Strömpl C, Abraham W (2004). «Phylogenetic relationships of the genera Stella, Labrys and Angulomicrobium within the 'Alphaproteobacteria' and description of Angulomicrobium amanitiforme sp. nov». Int J Syst Evol Microbiol 54 (Pt 3): 651-7. PMID 15143003. Archivado desde el original el 10 de octubre de 2008. Consultado el 13 de marzo de 2008.
- Cabeen M, Jacobs-Wagner C (2005). «Bacterial cell shape». Nat Rev Microbiol 3 (8): 601-10. PMID 16012516.
- Young K (2006). «The selective value of bacterial shape». Microbiol Mol Biol Rev 70 (3): 660-703. PMID 16959965.
- Douwes K, Schmalzbauer E, Linde H, Reisberger E, Fleischer K, Lehn N, Landthaler M, Vogt T (2003). «Branched filaments no fungus, ovoid bodies no bacteria: Two unusual cases of mycetoma». J Am Acad Dermatol 49 (2 Suppl Case Reports): S170-3. PMID 12894113.
- Donlan R (2002). «Biofilms: microbial life on surfaces». Emerg Infect Dis 8 (9): 881-90. PMID 12194761.
- Branda S, Vik S, Friedman L, Kolter R (2005). «Biofilms: the matrix revisited». Trends Microbiol 13 (1): 20-26. PMID 15639628.
- Davey M, O'toole G (2000). «Microbial biofilms: from ecology to molecular genetics». Microbiol Mol Biol Rev 64 (4): 847-67. PMID 11104821.
- Donlan RM, Costerton JW (2002). «Biofilms: survival mechanisms of clinically relevant microorganisms». Clin Microbiol Rev 15 (2): 167-93. PMID 11932229.
- Shimkets L. «Intercellular signaling during fruiting-body development of Myxococcus xanthus.». Annu Rev Microbiol 53: 525-49. PMID 10547700.
- Kaiser D. «Signaling in myxobacteria». Annu Rev Microbiol 58: 75-98. PMID 15487930.
- Harold F (1972). «Conservation and transformation of energy by bacterial membranes». Bacteriol Rev 36 (2): 172-230. PMID 4261111.
- Berg J., Tymoczko J. and Stryer L. (2002) Biochemistry. W. H. Freeman and Company ISBN 0-7167-4955-6
- Fuerst J (2005). «Intracellular compartmentation in planctomycetes». Annu Rev Microbiol 59: 299-328. PMID 15910279.
- Poehlsgaard J, Douthwaite S (2005). «The bacterial ribosome as a target for antibiotics». Nat Rev Microbiol 3 (11): 870-81. PMID 16261170.
- Yeo M, Chater K (2005). «The interplay of glycogen metabolism and differentiation provides an insight into the developmental biology of Streptomyces coelicolor». Microbiology 151 (Pt 3): 855-61. PMID 15758231.
- Shiba T, Tsutsumi K, Ishige K, Noguchi T (2000). «Inorganic polyphosphate and polyphosphate kinase: their novel biological functions and applications». Biochemistry (Mosc) 65 (3): 315-23. PMID 10739474.
- Brune DC. (1995). «Isolation and characterization of sulfur globule proteins from Chromatium vinosum and Thiocapsa roseopersicina». Arch Microbiol 163 (6): 391-99. PMID 7575095.
- Kadouri D, Jurkevitch E, Okon Y, Castro-Sowinski S. (2005). «Ecological and agricultural significance of bacterial polyhydroxyalkanoates». Crit Rev Microbiol 31 (2): 55-67. PMID 15986831.
- Walsby A (1994). «Gas vesicles». Microbiol Rev 58 (1): 94-144. PMID 8177173.
- Gitai, Z. (2005). «The New Bacterial Cell Biology: Moving Parts and Subcellular Architecture». Cell 120 (5): 577-586. doi:10.1016/j.cell.2005.02.026.
- Thanbichler M, Wang S, Shapiro L (2005). «The bacterial nucleoid: a highly organized and dynamic structure». J Cell Biochem 96 (3): 506-21. PMID 15988757.
- Gitai Z (2005). «The new bacterial cell biology: moving parts and subcellular architecture». Cell 120 (5): 577-86. PMID 15766522. doi:10.1016/j.cell.2005.02.026.
- Shih YL, Rothfield L (2006). «The bacterial cytoskeleton». Microbiol. Mol. Biol. Rev. 70 (3): 729-54. PMID 16959967. doi:10.1128/MMBR.00017-06.
- van Heijenoort J (2001). «Formation of the glycan chains in the synthesis of bacterial peptidoglycan». Glycobiology 11 (3): 25R-36R. PMID 11320055.
- Koch A (2003). «Bacterial wall as target for attack: past, present, and future research». Clin Microbiol Rev 16 (4): 673-87. PMID 14557293. Archivado desde el original el 28 de septiembre de 2008. Consultado el 21 de abril de 2007.
- Gram, HC (1884). «Über die isolierte Färbung der Schizomyceten in Schnitt- und Trockenpräparaten». Fortschr. Med. 2: 185-9.
- Hugenholtz P (2002). «Exploring prokaryotic diversity in the genomic era». Genome Biol 3 (2): REVIEWS0003. PMID 11864374.
- Walsh F, Amyes S (2004). «Microbiology and drug resistance mechanisms of fully resistant pathogens.». Curr Opin Microbiol 7 (5): 439-44. PMID 15451497.
- Engelhardt H, Peters J (1998). «Structural research on surface layers: a focus on stability, surface layer homology domains, and surface layer-cell wall interactions». J Struct Biol 124 (2-3): 276-302. PMID 10049812.
- Beveridge T, Pouwels P, Sára M, Kotiranta A, Lounatmaa K, Kari K, Kerosuo E, Haapasalo M, Egelseer E, Schocher I, Sleytr U, Morelli L, Callegari M, Nomellini J, Bingle W, Smit J, Leibovitz E, Lemaire M, Miras I, Salamitou S, Béguin P, Ohayon H, Gounon P, Matuschek M, Koval S (1997). «Functions of S-layers». FEMS Microbiol Rev 20 (1-2): 99-149. PMID 9276929.
- Kojima S, Blair D. «The bacterial flagellar motor: structure and function of a complex molecular machine». Int Rev Cytol 233: 93-134. PMID 15037363.
- Beachey E (1981). «Bacterial adherence: adhesin-receptor interactions mediating the attachment of bacteria to mucosal surface». J Infect Dis 143 (3): 325-45. PMID 7014727.
- Silverman P (1997). «Towards a structural biology of bacterial conjugation». Mol Microbiol 23 (3): 423-9. PMID 9044277.
- Stokes R, Norris-Jones R, Brooks D, Beveridge T, Doxsee D, Thorson L (2004). «The glycan-rich outer layer of the cell wall of Mycobacterium tuberculosis acts as an antiphagocytic capsule limiting the association of the bacterium with macrophages». Infect Immun 72 (10): 5676-86. PMID 15385466. Archivado desde el original el 29 de septiembre de 2008. Consultado el 21 de abril de 2007.
- Daffé M, Etienne G (1999). «The capsule of Mycobacterium tuberculosis and its implications for pathogenicity». Tuber Lung Dis 79 (3): 153-69. PMID 10656114.
- Finlay B, Falkow S (1997). «Common themes in microbial pathogenicity revisited». Microbiol Mol Biol Rev 61 (2): 136-69. PMID 9184008.
- Nicholson W, Munakata N, Horneck G, Melosh H, Setlow P (2000). «Resistance of Bacillus endospores to extreme terrestrial and extraterrestrial environments». Microbiol Mol Biol Rev 64 (3): 548-72. PMID 10974126.
- Siunov A, Nikitin D, Suzina N, Dmitriev V, Kuzmin N, Duda V. «Phylogenetic status of Anaerobacter polyendosporus, an anaerobic, polysporogenic bacterium». Int J Syst Bacteriol. 49 Pt 3: 1119-24. PMID 10425769. Archivado desde el original el 16 de junio de 2007.
- Nicholson W, Fajardo-Cavazos P, Rebeil R, Slieman T, Riesenman P, Law J, Xue Y (2002). «Bacterial endospores and their significance in stress resistance». Antonie Van Leeuwenhoek 81 (1-4): 27-32. PMID 12448702.
- Vreeland R, Rosenzweig W, Powers D (2000). «Isolation of a 250 million-year-old halotolerant bacterium from a primary salt crystal». Nature 407 (6806): 897-900. PMID 11057666.
- Cano R, Borucki M (1995). «Revival and identification of bacterial spores in 25- to 40-million-year-old Dominican amber». Science 268 (5213): 1060-4. PMID 7538699.
- Nicholson W, Schuerger A, Setlow P (2005). «The solar UV environment and bacterial spore UV resistance: considerations for Earth-to-Mars transport by natural processes and human spaceflight». Mutat Res 571 (1-2): 249-64. PMID 15748651.
- Hatheway C (1990). «Toxigenic clostridia». Clin Microbiol Rev 3 (1): 66-98. PMID 2404569.
- Nealson K (1999). «Post-Viking microbiology: new approaches, new data, new insights». Orig Life Evol Biosph 29 (1): 73-93. PMID 11536899.
- Xu J (2006). «Microbial ecology in the age of genomics and metagenomics: concepts, tools, and recent advances». Mol Ecol 15 (7): 1713-31. PMID 16689892.
- Zillig W (1991). «Comparative biochemistry of Archaea and Bacteria». Curr Opin Genet Dev 1 (4): 544-51. PMID 1822288.
- Hellingwerf K, Crielaard W, Hoff W, Matthijs H, Mur L, van Rotterdam B (1994). «Photobiology of bacteria». Antonie Van Leeuwenhoek 65 (4): 331-47. PMID 7832590.
- Zumft W (1997). «Cell biology and molecular basis of denitrification». Microbiol Mol Biol Rev 61 (4): 533-616. PMID 9409151.
- Drake H, Daniel S, Küsel K, Matthies C, Kuhner C, Braus-Stromeyer S (1997). «Acetogenic bacteria: what are the in situ consequences of their diverse metabolic versatilities?». Biofactors 6 (1): 13-24. PMID 9233536.
- Dalton H (2005). «The Leeuwenhoek Lecture 2000 the natural and unnatural history of methane-oxidizing bacteria». Philos Trans R Soc Lond B Biol Sci 360 (1458): 1207-22. PMID 16147517. (enlace roto disponible en Internet Archive; véase el historial, la primera versión y la última).
- Zehr J, Jenkins B, Short S, Steward G (2003). «Nitrogenase gene diversity and microbial community structure: a cross-system comparison». Environ Microbiol 5 (7): 539-54. PMID 12823187.
- Morel, FMM; Kraepiel AML, Amyot M (1998). «The chemical cycle and bioaccumulation of mercury». Annual Review of Ecological Systems 29: 543—566.
- Bardy S, Ng S, Jarrell K (2003). «Prokaryotic motility structures». Microbiology 149 (Pt 2): 295-304. PMID 12624192. Archivado desde el original el 14 de septiembre de 2007. Consultado el 1 de julio de 2007.
- Merz A, So M, Sheetz M (2000). «Pilus retraction powers bacterial twitching motility». Nature 407 (6800): 98-102. PMID 10993081.
- Wu M, Roberts J, Kim S, Koch D, DeLisa M (2006). «Collective bacterial dynamics revealed using a three-dimensional population-scale defocused particle tracking technique». Appl Environ Microbiol 72 (7): 4987-94. PMID 16820497. Archivado desde el original el 29 de septiembre de 2008. Consultado el 1 de julio de 2007.
- Lux R, Shi W (2004). «Chemotaxis-guided movements in bacteria». Crit Rev Oral Biol Med 15 (4): 207-20. PMID 15284186.
- Frankel R, Bazylinski D, Johnson M, Taylor B (1997). «Magneto-aerotaxis in marine coccoid bacteria». Biophys J 73 (2): 994-1000. PMID 9251816.
- Kaiser D. «Signaling in myxobacteria». Annu Rev Microbiol 58: 75-98. PMID 15487930.
- Goldberg MB (2001). «Actin-based motility of intracellular microbial pathogens». Microbiol Mol Biol Rev 65 (4): 595-626. PMID 11729265.
- Oteros J et al. (2019). «Artemisia pollen is the main vector for airborne endotoxin». Journal of Allergy and Clinical Immunology 143 (1): 367-377. PMID 30012513.
- Curtis-Barnes, Biología (1994). «7». Como se dividen las células. Medica Panamericana. p. 171. ISBN 950-06-0375-6.
- Koch A (2002). «Control of the bacterial cell cycle by cytoplasmic growth». Crit Rev Microbiol 28 (1): 61-77. PMID 12003041.
- Eagon R. «Pseudomonas natriegens, a marine bacterium with a generation time of less than 10 minutes». J Bacteriol 83: 736-7. PMID 13888946.
- Prats C, López D, Giró A, Ferrer J, Valls J (2006). «Individual-based modelling of bacterial cultures to study the microscopic causes of the lag phase». J Theor Biol 241 (4): 939-53. PMID 16524598.
- Hecker M, Völker U. «General stress response of Bacillus subtilis and other bacteria». Adv Microb Physiol 44: 35-91. PMID 11407115.
- Nakabachi A, Yamashita A, Toh H, Ishikawa H, Dunbar H, Moran N, Hattori M (2006). «The 160-kilobase genome of the bacterial endosymbiont Carsonella». Science 314 (5797): 267. PMID 17038615.
- Pradella S, Hans A, Spröer C, Reichenbach H, Gerth K, Beyer S (2002). «Characterisation, genome size and genetic manipulation of the myxobacterium Sorangium cellulosum So ce56». Arch Microbiol 178 (6): 484-92. PMID 12420170.
- Hinnebusch J, Tilly K (1993). «Linear plasmids and chromosomes in bacteria». Mol Microbiol 10 (5): 917-22. PMID 7934868.
- Brüssow H, Canchaya C, Hardt W (2004). «Phages and the evolution of bacterial pathogens: from genomic rearrangements to lysogenic conversion». Microbiol Mol Biol Rev 68 (3): 560-602. PMID 15353570.
- Perna N, Mayhew G, Pósfai G, Elliott S, Donnenberg M, Kaper J, Blattner F (1998). «Molecular evolution of a pathogenicity island from enterohemorrhagic Escherichia coli O157:H7». Infect Immun 66 (8): 3810-7. PMID 9673266.
- Denamur E, Matic I (2006). «Evolution of mutation rates in bacteria». Mol Microbiol 60 (4): 820-7. PMID 16677295.
- Wright B (2004). «Stress-directed adaptive mutations and evolution». Mol Microbiol 52 (3): 643-50. PMID 15101972.
- Davison J (1999). «Genetic exchange between bacteria in the environment». Plasmid 42 (2): 73-91. PMID 10489325.
- Hastings P, Rosenberg S, Slack A (2004). «Antibiotic-induced lateral transfer of antibiotic resistance». Trends Microbiol 12 (9): 401-4. PMID 15337159.
- Stams A, de Bok F, Plugge C, van Eekert M, Dolfing J, Schraa G (2006). «Exocellular electron transfer in anaerobic microbial communities». Environ Microbiol 8 (3): 371-82. PMID 16478444.
- Barea J, Pozo M, Azcón R, Azcón-Aguilar C (2005). «Microbial co-operation in the rhizosphere». J Exp Bot 56 (417): 1761-78. PMID 15911555.
- IGER. Ciencias Naturales: Zaculeu. IGER. ISBN 9789929614116. Consultado el 5 de septiembre de 2017.
- O'Hara A, Shanahan F (2006). «The gut flora as a forgotten organ». EMBO Rep 7 (7): 688-93. PMID 16819463.
- Zoetendal E, Vaughan E, de Vos W (2006). «A microbial world within us». Mol Microbiol 59 (6): 1639-50. PMID 16553872.
- Gorbach S (1990). «Lactic acid bacteria and human health». Ann Med 22 (1): 37-41. PMID 2109988.
- Salminen S, Gueimonde M, Isolauri E (2005). «Probiotics that modify disease risk». J Nutr 135 (5): 1294-8. PMID 15867327.
- Erin Gill & Fiona Brinkman 2011, The proportional lack of archaeal pathogens: Do viruses/phages hold the key? Bioessays. 2011 April; 33(4): 248–254.
- Fish D. «Optimal antimicrobial therapy for sepsis». Am J Health Syst Pharm. 59 Suppl 1: S13-9. PMID 11885408.
- Belland R, Ouellette S, Gieffers J, Byrne G (2004). «Chlamydia pneumoniae and atherosclerosis». Cell Microbiol 6 (2): 117-27. PMID 14706098.
- Heise E. «Diseases associated with immunosuppression». Environ Health Perspect 43: 9-19. PMID 7037390.
- Saiman, L (2004). «Microbiology of early CF lung disease». Paediatr Respir Rev.volumen=5 Suppl A: S367-369. PMID 14980298
- Yonath A, Bashan A (2004). «Ribosomal crystallography: initiation, peptide bond formation, and amino acid polymerization are hampered by antibiotics». Annu Rev Microbiol 58: 233-51. PMID 15487937.
- Khachatourians G (1998). «Agricultural use of antibiotics and the evolution and transfer of antibiotic-resistant bacteria». CMAJ 159 (9): 1129-36. PMID 9835883.
- Thomson R, Bertram H (2001). «Laboratory diagnosis of central nervous system infections». Infect Dis Clin North Am 15 (4): 1047-71. PMID 11780267.
- Boucher Y, Douady CJ, Papke RT, Walsh DA, Boudreau ME, Nesbo CL, Case RJ, Doolittle WF (2003). «Lateral gene transfer and the origins of prokaryotic groups.». Annu Rev Genet 37: 283-328. PMID 14616063.
- Olsen G, Woese C, Overbeek R (1994). «The winds of (evolutionary) change: breathing new life into microbiology». J Bacteriol 176 (1): 1-6. PMID 8282683.
- Tindall, BJ, Trüper, HG (28 de noviembre de 2005). «The Role of the ICSP (International Committee on Systematics of Prokaryotes) in the Nomenclature and Taxonomy of Prokaryotes» (en inglés). ICSP. Archivado desde el original el 19 de agosto de 2007. Consultado el 2 de septiembre de 2008.
- Euzéby, JP (2008). «List of Prokaryotic names with Standing in Nomenclature (LPSN)» (en inglés). Archivado desde el original el 30 de diciembre de 2010. Consultado el 2 de septiembre de 2008.
- «EMInternational Journal of Systematic Bacteriology (IJS)» (en inglés). Society for General Microbiology. Consultado el 2 de septiembre de 2008.
- «Bergey's Manual Trust» (en inglés). 26 de agosto. Consultado el 2 de septiembre de 2008.
- «The Taxonomic Outline of Bacteria and Archaea, TOBA release 7.7» (en inglés). Universidad Estatal de Míchigan en colaboración con NamesforLife, LLC. 2007. Archivado desde el original el 1 de diciembre de 2008. Consultado el 2 de septiembre de 2008.
- Rappé MS, Giovannoni SJ (2003). "The uncultured microbial majority". Annual Review of Microbiology 57: 369–94. doi:10.1146/annurev.micro.57.030502.090759
- Doolittle RF (2005). «Evolutionary aspects of whole-genome biology». Curr Opin Struct Biol 15 (3): 248-253. PMID 11837318.
- Gram, HC (1884). «Über die isolierte Färbung der Schizomyceten in Schnitt- und Trockenpräparaten». Fortschr. Med. 2: 185-189.
- Ryan KJ; Ray CG (editors) (2004). Sherris Medical Microbiology (4th ed. edición). McGraw Hill. pp. 232–3. ISBN 0-8385-8529-9.
- Madigan, MT; Martinko J; Parker J (2004). Brock Biology of Microorganisms (10th Edition edición). Lippincott Williams & Wilkins. ISBN 0-13-066271-2.
- Beveridge, T.J.; Davies, J.A. «Cellular responses of Bacillus subtilis and Escherichia coli to the Gram stain» (PDF). J. Bacteriol. 156 (2): 846-858. PMID 6195148. Archivado desde el original el 5 de octubre de 2011. Consultado el 2007 de febrero de 17.
- Davies, J.A.; G.K. Anderson, T.J. Beveridge, H.C. Clark. «Chemical mechanism of the Gram stain and synthesis of a new electron-opaque marker for electron microscopy which replaces the iodine mordant of the stain» (PDF). J. Bacteriol. 156 (2): 837-845. PMID 6195147. Archivado desde el original el 5 de octubre de 2011. Consultado el 2007 de febrero de 17.
- Cheryl P. Andam & J. Peter Gogarten 2011. Biased gene transfer in microbial evolution. Figure 1 --| Phylogenetic analysis of bacterial tyrosyl-tRNA synthetase amino acid sequences and the corresponding concatenated 16S–23S ribosomal RNA phylogeny. Nature Reviews Microbiology 9, 543-555 doi:10.1038/nrmicro2593
- Gupta, R. S. (2005). Molecular Sequences and the Early History of Life. In "Microbial Phylogeny and Evolution: Concepts and Controversies" (J. Sapp, Ed.), Oxford University Press, New York. Web: Branching Order of Bacterial Phyla.
- Boussau, Bastien et al 2008. Accounting for horizontal gene transfers explains conflicting hypotheses regarding the position of aquificales in the phylogeny of Bacteria. BMC Evolutionary Biology, 8:272 doi:10.1186/1471-2148-8-272
- Brown, C. T., Hug, L. A., Thomas, B. C., Sharon, I., Castelle, C. J., Singh, A., ... & Banfield, J. F. (2015). Unusual biology across a group comprising more than 15% of domain Bacteria. Nature, 523(7559), 208-211.
- Donovan H. Parks, Maria Chuvochina, David W. Waite, Christian Rinke, Adam Skarshewski, Pierre-Alain Chaumeil, Philip Hugenholtz (2018). A proposal for a standardized bacterial taxonomy based on genome phylogeny. Biorxiv.
- Johnson M, Lucey J (2006). «Major technological advances and trends in cheese». J Dairy Sci 89 (4): 1174-8. PMID 16537950.
- Hagedorn S, Kaphammer B. «Microbial biocatalysis in the generation of flavor and fragrance chemicals». Annu Rev Microbiol 48: 773-800. PMID 7826026.
- Cohen Y (2002). «Bioremediation of oil by marine microbial mats». Int Microbiol 5 (4): 189-93. PMID 12497184.
- Neves L, Miyamura T, Moraes D, Penna T, Converti A. «Biofiltration methods for the removal of phenolic residues». Appl Biochem Biotechnol. 129–132: 130-52. PMID 16915636.
- Liese A, Filho M (1999). «Production of fine chemicals using biocatalysis». Curr Opin Biotechnol 10 (6): 595-603. PMID 10600695.
- Aronson A, Shai Y (2001). «Why Bacillus thuringiensis insecticidal toxins are so effective: unique features of their mode of action». FEMS Microbiol Lett 195 (1): 1-8. PMID 11166987.
- Bozsik A (2006). «Susceptibility of adult Coccinella septempunctata (Coleoptera: Coccinellidae) to insecticides with different modes of action». Pest Manag Sci 62 (7): 651-4. PMID 16649191.
- Chattopadhyay A, Bhatnagar N, Bhatnagar R (2004). «Bacterial insecticidal toxins». Crit Rev Microbiol 30 (1): 33-54. PMID 15116762.
- Serres M, Gopal S, Nahum L, Liang P, Gaasterland T, Riley M (2001). «A functional update of the Escherichia coli K-12 genome». Genome Biol 2 (9): RESEARCH0035. PMID 11574054.
- Almaas E, Kovács B, Vicsek T, Oltvai Z, Barabási A (2004). «Global organization of metabolic fluxes in the bacterium Escherichia coli». Nature 427 (6977): 839-43. PMID 14985762.
- Reed J, Vo T, Schilling C, Palsson B (2003). «An expanded genome-scale model of Escherichia coli K-12 (iJR904 GSM/GPR)». Genome Biol 4 (9): R54. PMID 12952533. Archivado desde el original el 29 de enero de 2016. Consultado el 14 de junio de 2007.
- Walsh G (2005). «Therapeutic insulins and their large-scale manufacture». Appl Microbiol Biotechnol 67 (2): 151-9. PMID 15580495.
- Graumann K, Premstaller A (2006). «Manufacturing of recombinant therapeutic proteins in microbial systems». Biotechnol J 1 (2): 164-86. PMID 16892246.
Enlaces externos
Wikimedia Commons alberga una categoría multimedia sobre Bacteria.
Wikispecies tiene un artículo sobre Bacteria.
Wikcionario tiene definiciones y otra información sobre bacteria.











